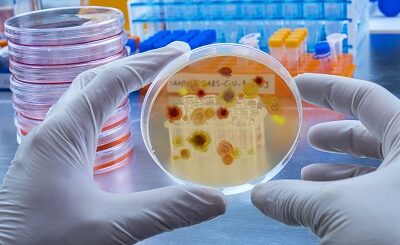
грибки и вирусы

Масло черного тмина от камней в почках: способы применения
Диагноз мочекаменной болезни никогда не бывает случайным. Камни в почках формируются постепенно, их появлению предшествуют разные причины. Это воспалительные болезни почек, инфекции, нарушения обмена веществ, подагра, неправильное питание и вредные привычки. Если человек регулярно обследуется, можно «поймать» начало мочекаменной болезни и предупредить ее. Для этого корректируют диету, назначают медикаментозную терапию. Хороший эффект дают народные средства, отлично помогает черный тмин от камней, различные травяные сборы. Мы предлагаем поговорить о мочекаменной болезни (МКБ), и о том, как можно с ней справиться с помощью натурального продукта Alhadaya.
Причины образования камней в почках
Камни в почках формируются не только в результате хронических болезней. Существуют и внешние факторы, приводящие к появлению в моче «песка», из которого позже формируются конкременты. К ним относятся:
- Плохое качество питьевой воды. Вода, богатая солями и примесями вредна для организма и особенно для выделительной системы.
- Повышенное потоотделение и малое количество питья. Когда человек часто и обильно потеет, не возмещая объем потерянной жидкости, моча становиться более концентрированной, что в ней увеличивается количество камнеообразующих элементов. По причине повышенного потоотделения приступы почечной колики чаще встречаются у людей, живущих в жарком климате.
- Диеты и определенные пищевые пристрастия. Питание с высоким содержанием белка, соли, сахара способствует образованию камней.
- Злоупотребление продуктами с кальцием. Этот «грех» характерен для пожилых женщин. Многие из них злоупотребляют творогом и молоком, обогащенных кальцием. Польза здесь сомнительная – с одной стороны продукты укрепляют кости и зубы, с другой – успешно формируют кальциевые камни в почках.
Почечные конкременты образуются и в результате болезней, вот их перечень:
- Нарушения обмена веществ, и связанные с ним патологии – ожирение, сахарный диабет, гиперпаратиреоз, подагра.
- Последствия хирургических вмешательств на желудочно–кишечном тракте.
- Острые и хронические заболевания почек, врожденные дефекты выделительной системы – пиелиты, циститы, пиелонефриты, сужение мочеточников и другие.
- Наследственная предрасположенность.
- Наличие мочекаменной болезни в анамнезе.
- Инфекции почек и мочевыводящих путей.
Главное осложнение мочекаменной болезни – колика. Это опасное и крайне болезненное состояние, которое не купируется с помощью домашних средств. Проще не допустить приступ, чем с ним справиться. Мы предлагаем поговорить о свойствах черного тмина и том, как употреблять продукт с целью профилактики и лечения МКБ.
Как может помочь масло черного тмина
Семена тмина известны современному населению в качестве ароматной приправы. Растение упоминается в истории Древнего Египта, где его ценили не только за вкусовые качества, но и за лечебные свойства. Экстракт семян использовали для приготовления масла, которое называли «золотом фараонов». Арабское название черного тмина (чернушки, зиры, кумина, седана, джиры) звучит как «семя благословения». Древние наделяли масло тмина волшебными свойствами и считали, что оно лечит все, за исключением смерти.
Современная народная медицина широко применяет масло тмина для укрепления иммунитета, лечения болезней дыхательной и сердечно-сосудистой, пищеварительной системы, профилактики онкологии. При болезнях почек и мочевыводящих путей масло тмина Alhadaya назначают с противовоспалительной и лечебной целью.
- Важно! Натуральное масло готовят методом холодного отжима, что позволяет максимально сберечь полезные свойства растения.
Вот основные характеристики масла Alhadaya:
- обладает мочегонным свойством, что способствует устранению застоя мочи и растворению камней;
- помогает при частых мочеиспусканиях, облегчает состояние при циститах;
- укрепляет иммунитет, помогает бороться с инфекциями мочевых путей;
- содержит витамины, микро-макро-элементы, эфирные масла, обладает антиоксидантными свойствами, борется со свободными радикалами, предупреждая новообразования;
- выводит токсины, шлаки, вредные вещества;
- улучшает обмен, что стимулирует деятельность всех органов и систем.
С древности масло тмина ценят как омолаживающее средство, оно тонизирует кожу, разглаживает морщины, улучшает цвет лица и состояние волос. Показано и местное применение Alhadaya для примочек и компрессов для устранения боли и отеков.
Способ применения
Применяют масло тмина разными способами, в зависимости от цели и назначения.
- Для укрепления защитных сил организма рекомендуется в течение 3 месяцев пить по одной чайной ложке масла по утрам. Лучше запивать лекарство кипяченой водой комнатной температуры.
- Важно! Применение продукта в педиатрии должно быть согласовано с врачом! Детям до года масло не показано!
- С жаропонижающей целью добавьте 5 – 7 капель масла в травяной чай – липовый, ромашковый.
- При недержании мочи и частом мочеиспускании 1 чайную ложку Alhadaya принимают трижды в сутки в течение острого периода болезни.
- Для растворения почечных камней рекомендуют принимать масло тмина, смешав его с медом. Смесь запивают водой. Есть вариант и применения семян тмина с сахаром.
Общий оздоровительный эффект натурального продукта делает его значимым помощником для пациентов, которые страдают хроническими патологиями почек.
Методы профилактики
Профилактика болезней почек начинается с раннего детства. Уже в роддоме малышам проводят скрининг с целью выявления патологий мочевыделительной системы. Если врожденных патологий не обнаружено, имеет значение регулярное медицинское наблюдение. Это важно и для детей, и для взрослых.
Помните о достаточном количестве питья в день. Взрослым следует выпивать не менее 1,5 литров воды в день, причем чай, кофе, компоты и другие напитки водой не считаются.
Ограничьте потребление поваренной соли до 5-6 граммов в сутки. Соль обладает способностью задерживать воду, формирует отеки, повышает артериальное давление. Пересоленная пища, любовь к копченостям и маринадам, злоупотребление кофе, алкоголем, курение заставляют почки работать с повышенной нагрузкой и приводят к образованию конкрементов.
Употребляйте в пищу природные уроантисептики – клюквы, бруснику.
Не игнорируйте боли в пояснице, обязательно обращайтесь к врачу. Любые боли в пояснице следует дифференцировать от почечных болей.
Избавляйтесь от лишнего веса грамотно, не идите на голодных диетах, больше двигайтесь.
Сохранить собственное здоровье не трудно, для этого нужно вести правильный образ жизни. Рациональное питание, достаточная двигательная активность, полноценный отдых, регулярная утренняя гимнастика помогут вам оставаться бодрыми и работоспособными долгие годы. В помощь возьмите масло черного тмина Alhadaya организм будет вам благодарен.